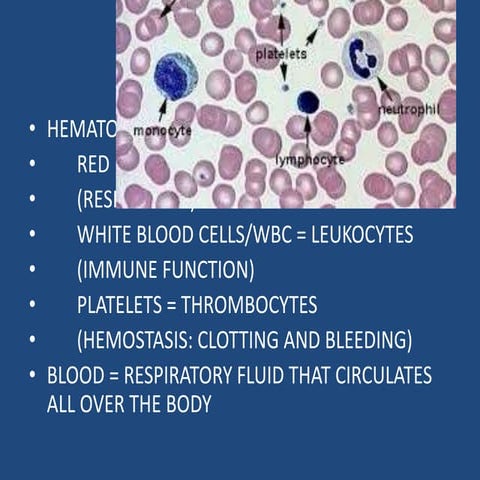
INTRODUCTION TO CLINICAL HEMATOLOGY powerpoint Biology Diagrams

Hematology Biology Diagrams 10.4 Anatomy of the Hematology System The hematology system consists of the blood and the bone marrow that create the cellular elements of the blood, as well as accessory organs, including the spleen and the liver. A blood transfusion (blŭd tran-SFŪ-zhŏn) is a procedure that enables the transfer of blood products from one person to another. Blood makes up about 8% of the human body weight. It contains erythrocytes, leucocytes, thrombocytes (platelets) and plasma. The volume percentage of all blood cells in the whole blood is about 45% of adults (hematocrit). The rest consists of liquid plasma (e.g. water, plasma proteins, electrolytes etc.). Learning anatomy is a massive

The pH of blood averages about 7.4; however, it can range from 7.35 to 7.45 in a healthy person. Blood is therefore somewhat more basic (alkaline) on a chemical scale than pure water, which has a pH of 7.0. Blood contains numerous buffers that help to regulate pH. Blood constitutes approximately 8 percent of adult body weight.

18.1 Functions of Blood Biology Diagrams
Blood is the body fluid in humans and other animals that delivers the essential materials for life to the body's cells. It has sometimes been called a fluid "tissue," because like solid tissues it contains several types of cells which perform complex functions for the human body. Cardiovascular System The cardiovascular system consists of the heart, blood vessels, and the approximately 5 liters of blood that the blood vessels transport. Digestive System The digestive system is a group of organs working together to convert food into energy and basic nutrients to feed the entire body.

• Erythrocytes are the major factor contributing to blood viscosity. • When the number of Erythrocytes increases beyond the normal range, blood becomes more viscous and flows more slowly. • When the number of Erythrocytes drops below the lower end of the range, the blood thins and flows more rapidly Erythrocytes count Dr. Naim Kittana, PhD 16

Blood (Anatomy): Function, Components, Types ... Biology Diagrams
Red Blood Cells. Red blood cells (rĕd blŭd sĕls) (RBCs) transport oxygen and carbon dioxide between tissues and the lungs. RBCs are packed with hemoglobin (HĒM-ō-glō-bin) (Hgb), a protein molecule that carries oxygen.For this reason, deficiency in RBCs results in symptoms related to decreased oxygenation of the body's tissues and organs. [6] See Figure 10.2 [7] for an illustration of

Recall that blood is a connective tissue. Like all connective tissues, it is made up of cellular elements and an extracellular matrix. The cellular elements—referred to as the formed elements —include red blood cells (RBCs), white blood cells (WBCs), and cell fragments called platelets.The extracellular matrix, called plasma, makes blood unique among connective tissues because it is fluid. AMA Citation Anatomy & Physiology in Hematology. In: Huppert LA, Dyster TG. Huppert L.A., & Dyster T.G.(Eds.), Eds. Laura A. Huppert, and Timothy G. Dyster. eds. Huppert's Notes: Pathophysiology and Clinical Pearls for Internal Medicine. McGraw Hill; 2021. Normal human hematopoesis. The multipotential hematopoietic stem cell can
18.1 An Overview of Blood Biology Diagrams
Dive into the life-giving essence of blood anatomy and physiology. Nursing students, here's your roadmap to understanding the vital river that courses through us, carrying both life and messages. Functions of the Blood. Blood is unique; it is the only fluid tissue in the body. 1. Carrier of gases, nutrients, and waste products.
